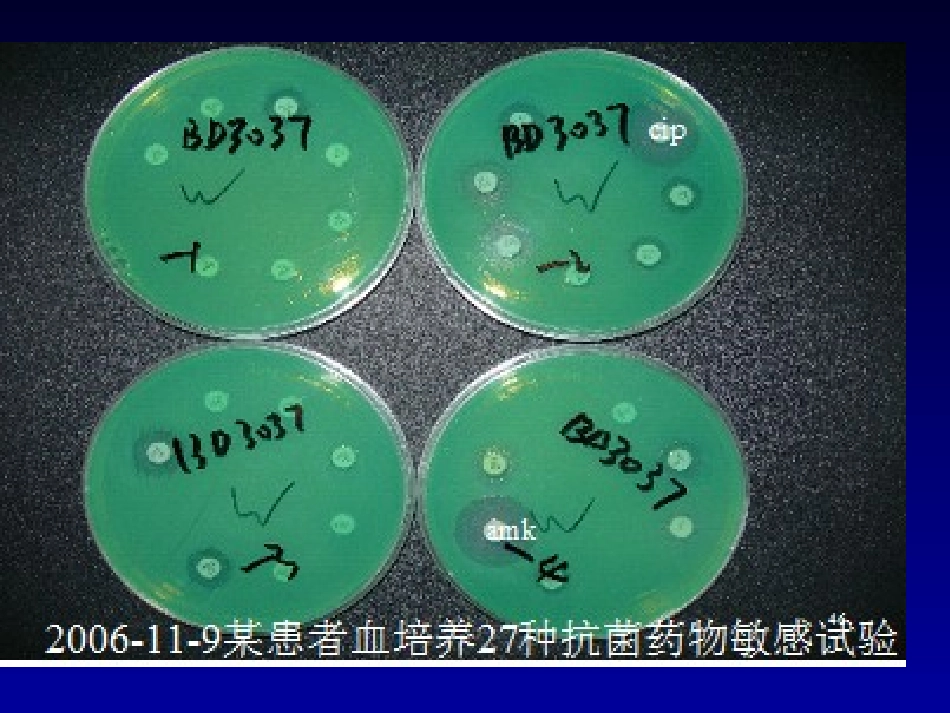
CLSI血培养--王瑶_第3页

1提高感染疾病的诊治水平-----关注CLSI血培养指南王瑶北京协和医院检验科临床微生物专业组MakeempiricalMakeempiricaltherapymoretherapymoreeffectiveeffectivePatient
Etiology
Resistance
cipamk全球关注的多重耐药菌•产ESBL的肠杆菌科菌•产KPC的肠杆菌科菌•MRSA•VRE•MDRPA•CRABAPUMCH痰标本前10位的菌株OrganismNumber%Acinetobacterbaumannii45521Pseudomonasaeruginosa36416Staphy
aureus26112Kleb
pneumoniae1718Candidaalbicans1436Escherichiacoli1065Steno
maltophilia1025Enterobactercloacae583Haemophilusinfluenzae412Enterococcusfaecalis382呼吸道痰标本分离的471株鲍曼不动杆菌的耐药性分析Antibioticname%R%I%SMinocycline31
3Cefoperazone/Sulbactam49
2Imipenem69
8Meropenem72
8Levofloxacin73
3Ampicillin/Sulbactam75
921Amikacin77
4Cefepime77
5Piperacillin/Tazobactam78
8Ciprofloxacin800
4Trimethoprim/Sulfamethoxazole80
619Ceftazidime80